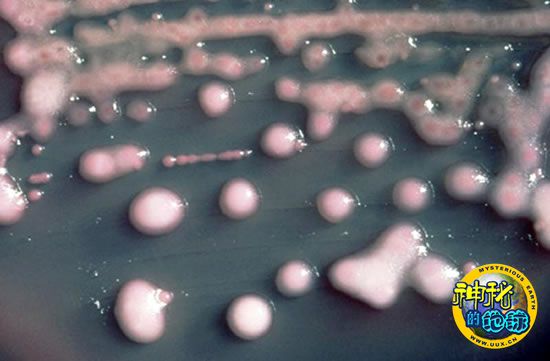

培养皿中的克雷伯氏肺炎杆菌会弄臭你的嘴
培养皿中的克雷伯氏肺炎杆菌会弄臭你的嘴
一种著名漱口水的广告语这样写道:“即便最好的朋友也不忍提醒你。”但是如果你的嘴真的很“臭”,OkayToKiss却会坦率地告诉你。
这项正处于专利审理过程中的新的唾液测试技术是由以色列特拉维夫大学的微生物学家Mel Rosenberg开发的——如果检测到很高数量的某种细菌酶,测试的结果便会呈现出蓝色。最新一期《呼吸研究杂志》介绍了与这项技术相关的新产品。过去,一种微生物群落——革兰氏阴性细菌——为这种“龙的气息”背负了全部的罪名。但是Rosenberg和他的研究小组在对培育的唾液样本中的细菌进行分析后发现,其他的一些主要细菌群落,例如革兰氏阳性细菌,通过形成特殊的酶——使得革兰氏阴性细菌能够更为容易地将蛋白质分解为发出恶臭的化合物——而加速了这一过程。
Rosenberg表示,OkayToKiss是有关气味的微生物学研究迅猛发展的一个副产品。在上周于宾夕法尼亚州费城召开的美国微生物学学会有关这一领域的第一次座谈会上,Rosenberg与大约150名科学家对这些造成肥料、牲畜和宠物的气味以及肠胃气胀的微小生物进行了讨论。座谈会的组织者、伊利诺伊州皮奥里亚市美国农业部的微生物学家Terence Whitehead表示:“无论在口腔中、在肥料中,或者在肠道中……为了想办法抑制这些细菌,你需要知道究竟是谁生活在这里。”Whitehead强调指出,当他和同事最近对猪粪中的细菌进行分析时,他们发现“大约90%的细菌是人们之前所不知道的。”
EurekAlert!